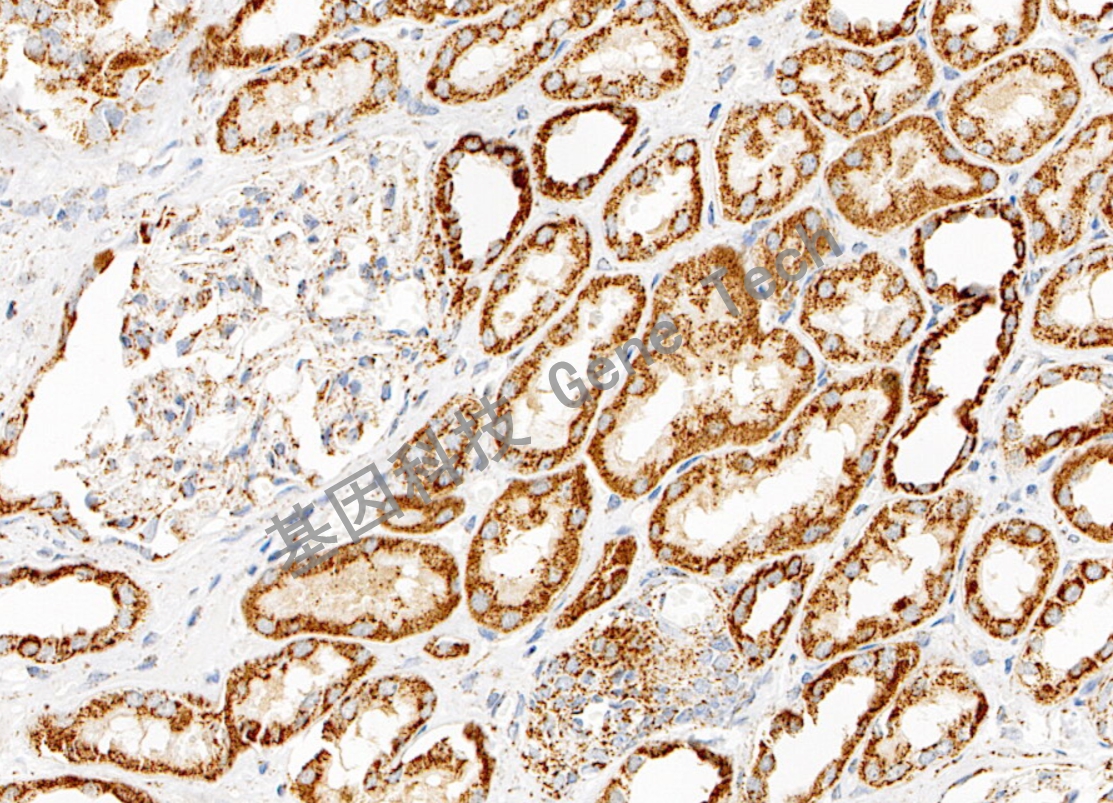
1724063916124115.jpg

產(chǎn)品中心
Products
免疫組織化學(xué)(IHC)
基因突變及甲基化檢測
熒光原位雜交(FISH)
原位雜交(ISH)
FH 鼠抗人 FH?抗體試劑(免疫組織化學(xué)法)
瀏覽次數(shù):2154 發(fā)布時間:2019-12-13
| 滬閔械備20220017號 | ||
| 克隆號:J-13 | 種屬:鼠 | 適用染色系統(tǒng):GTvisionTM |
| 預(yù)處理:高pH熱修復(fù) | 陽性部位:細(xì)胞漿 | 陽性對照:腎癌 |
| 簡介:FH(延胡索酸水合酶)是參與三羧酸循環(huán)的一個關(guān)鍵酶,在細(xì)胞內(nèi)能夠催化延胡索酸轉(zhuǎn)變成L-蘋果酸。遺傳性平滑肌瘤病及腎細(xì)胞癌(hereditary leiomyomatosis and renal cell cancer,HLRCC)綜合征患者是FH編碼基因發(fā)生突變所致,同時該患者也有罹患皮膚多發(fā)性平滑肌瘤和子宮平滑肌瘤的風(fēng)險。HLRCC相關(guān)腎細(xì)胞癌通常就診時分期高,具侵襲性,臨床預(yù)后差。 | ||
![]() | ||
| 腎癌石蠟切片,用 FH(GT2444)染色,細(xì)胞漿陽性,DAB 顯色。 | ||
| 貨號 | GT244402 | GT244407 | GT244429 |
| 規(guī)格 | 2.0ml | 7.0ml | 0.2ml濃縮液 |